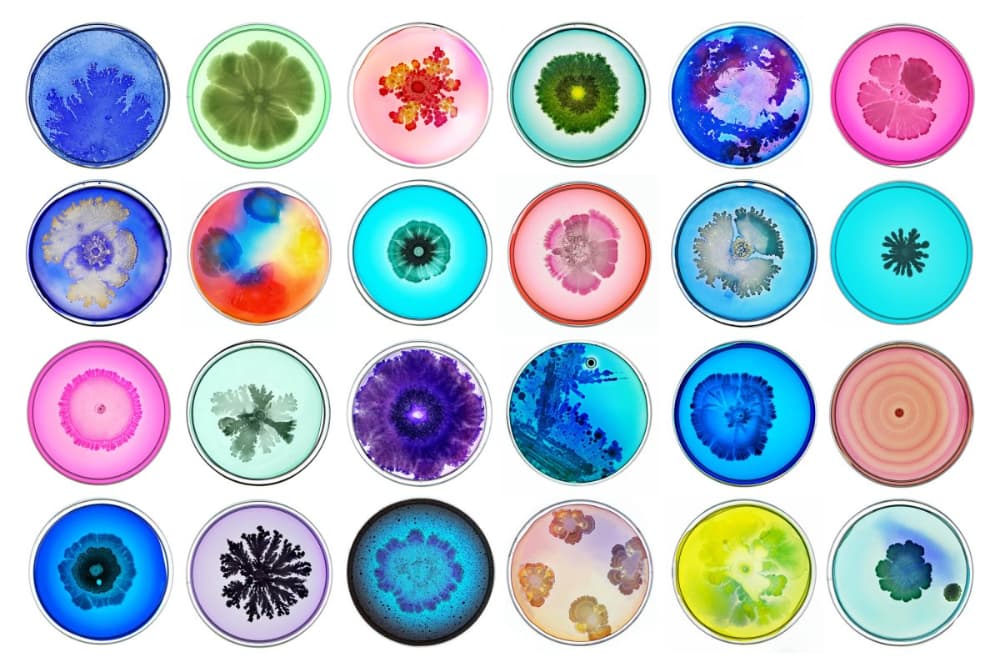
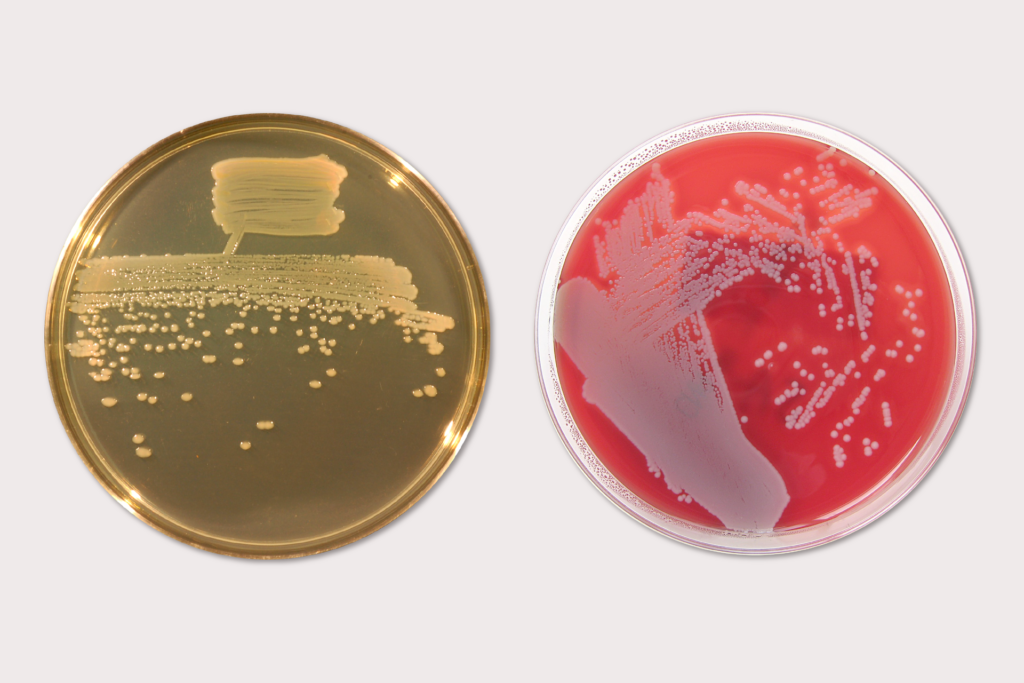

Зміст
- 1 Наземні середовища проживання
- 2 Прісноводні середовища проживання
- 3 Морські середовища проживання
- 4 Середовища існування бактерій
- 5 1. Середовище існування бактерій
- 6 2. Різноманітність бактерій
- 7 3. Живлення бактерій
- 8 4.Дихання бактерій
- 9 5. Розмноження бактерій
- 10 6. Значення бактерій
- 11 Середовище існування риб
- 12 Різноманітність середовища існування
- 13 Здорові популяції риб потребують хорошого середовища проживання
- 14 Середовище існування тварин
- 15 Що таке Хабітат?
- 16 Що таке мікрожиттєдіяльність?
- 17 Які існують типи середовищ існування?
- 18 Часті запитання про середовище проживання тварин
Середовище існування – це певний тип середовища, ідеальне для існування та росту певних рослин і тварин. Середовища існування або біоми визначаються кліматом і географією регіону, а також тваринами та рослинами, що населяють територію. Більшість видів тварин і птахів пристосовані до виживання в певних середовищах існування і не можуть жити в інших типах середовищ існування.

Наприклад, моржі пристосовані жити в морських середовищах існування і не можуть вижити в пустелях або інших наземних середовищах існування. Так само гримучі змії не можуть жити в морських водах або арктичних регіонах, оскільки вони пристосовані до теплих наземних середовищ існування, таких як луки та пустелі. Тварини, що живуть в екстремально холодних місцях проживання, можуть мігрувати в теплі регіони протягом зими, повертаючись до своїх вихідних місць проживання знову в теплу пору року.
У цій статті йдеться про різні типи середовищ існування та тварин, які в них мешкають.
Наземні середовища проживання
Наземні середовища існування стосуються всіх типів наземних середовищ існування, які зустрічаються по всьому світу. Існують численні типи наземних середовищ існування, у тому числі згадані нижче:
Луки (савани та прерії)
Луки — ще один тип середовища проживання з великою різноманітністю видів тварин і птахів. Існує 2 типи луків, тропічні та помірні. Африканська савана є прикладом тропічних пасовищ з такими тваринами, як леви, жирафи, слони, зебри та носороги, що живуть у цій місцевості. Луги помірного клімату є домом для таких тварин, як олені, газелі, миші, кролики та різні змії.
Тропічний ліс
Середовища існування тропічного лісу поділяються на кілька шарів або шарів від поверхні ґрунту до пологу лісу.
Лісова підстилка: у нижньому шарі цього середовища проживання живуть такі тварини, як окапі, тапір, суматранський носоріг, західна рівнинна горила, а також різні земноводні, рептилії та комахи.
Підлісок: різні ссавці , птахи, рептилії та комахи населяють цей другий шар середовища існування тропічного лісу. У цьому шарі зустрічаються такі тварини, як леопарди, удави та отруйні жаби.
Пологовий шар: Пологовий шар населений численними видами членистоногих, а також іншими видами, такими як африканський сірий папуга, кіледзьобий тукан, павукоподібна мавпа та трипалий лінивець.
Емерджентний шар: цей шар складається з дуже високих дерев і є домівкою для різноманітних видів тварин і птахів, зокрема вінценосного орла, великої летючої лисиці та королівського колобуса.
Пустелі
Пустелі — це широкі посушливі регіони з невеликою кількістю опадів і незначною кількістю рослинності або без неї. Тварини, що мешкають у пустелі, пристосовані до надзвичайно спекотної та вологої погоди і можуть тривалий час виживати без води. Вони мають спеціальні адаптивні властивості для використання невеликої кількості води, доступної в їхньому середовищі існування. Койот, кенгуровий щур, кролик і різні види ящірок є одними з поширених десертних тварин.
Гори
Гірське середовище проживання може бути надзвичайно суворим із недостатньою доступністю їжі та дуже холодним кліматом. Багато видів тварин розвинули спеціальні адаптивні властивості, щоб вижити в цьому типі середовища проживання. До них відносяться гірські козли, гірські леви, великі рогові вівці, антилопи та різні види ведмедів.
Прісноводні середовища проживання
Прісна вода становить близько 3% води на землі. Проте лише 0,014% загального обсягу прісної води існує у формі озер, річок і боліт у вигляді поверхневих вод.
Річки і струмки
Види тварин, що живуть у цьому типі середовища існування, потребують спеціальних адаптаційних особливостей, щоб справлятися з водою, що постійно тече в одному напрямку. У таких водоймах, як річки, струмки та джерела, мешкає велика кількість тварин, птахів і риб, таких як річкова видра, дельфіни, річкова черепаха, американський крокодил, лебідь-кликун, чорногорлий водолаз, крижні та червоночерева піранья.
Озера і ставки
Цей тип біома ідеально підходить для широкого кола видів тварин. Багато з цих водойм мають самостійну екологію, яка навіть може перетворити їх на еволюційні мікрокосми. Лосось, форель, піраруку, звичайна ропуха, великий чубатий тритон, зимородок, великий фламінго та качкодзьоб — це деякі види, які мешкають у цих прісноводних середовищах існування.
Водно-болотні угіддя
Водно-болотні угіддя включають болота, болота, болота, болота, а також заболочені території, де мешкають численні рептилії, земноводні, птахи, риби та ссавці. Деякі тварини, що живуть у цих біомах, включають лебідь-шипун, жайворонок, вуж, пальчатий тритон, сом, метелик-махаон і семиточкове сонечко.
Солонувата вода
Солонувата вода відноситься до водойм, які містять суміш солоної та прісної води. Ці водойми утворюються там, де прісна вода зустрічається з морською в таких місцях, як дельти, мангрові болота та естуарії. У солонуватих водах мешкають певні водні ссавці, риби, птахи та комахи, у тому числі звичайний тюлень, земляна акула, скат, лелека, лісовий павук тощо.
Морські середовища проживання
Близько 71% поверхні Землі вкрито океанами. Еволюція морського життя почалася приблизно за 3 мільярди років до земного життя. Тим не менш, недостатньо досліджень та інформації щодо океанських середовищ існування та їхніх мешканців.
Відкритий океан
Відкритий океан відноситься до освітленого сонцем верхнього шару океану за межами континентальних шельфів. Цей тип середовища існування іноді називають «морським десертом» через брак поживних речовин для підтримки життя порівняно з глибшими водами. Тварини, які зустрічаються у відкритому океані, включають синього кита, морську свиню, нарвала, чорнобрового альбатроса, оливкову черепаху, акул, скатів, летючих риб і лососів.
Коралові рифи
Коралові рифи можна визначити як підводні структури, побудовані з карбонату кальцію, виділеного коралами. Більшість цих рифів побудовані з кам’янистих коралів, які складаються з груп поліпів. Коралові рифи є домом для багатьох морських видів, включаючи звичайних чорносмугих морських крайтів, риб-жаб, листяних і бур’янистих морських драконів, морських зірок, бичків тощо.
Глибокий океан
Це середовище існування – це найглибший шар океану під континентальними шельфами. У темних глибинах океану немає сонячного світла, водоростей чи рослин. Види тварин, що живуть у цьому середовищі існування, мають численні особливі адаптивні особливості, щоб вижити, оскільки глибокий океан не підтримує нормальний харчовий ланцюг. У глибоких океанах водяться морські вудилки, лопастепері риби, лучепері риби та різноманітні акули.
Гідротермальні джерела
Гідротермальні джерела, такі як джерела теплої води, білі та чорні курці, утворюються, коли вода, нагріта якоюсь вулканічною діяльністю, проростає з-під морського дна. Один цікавий факт про гідротермальні джерела полягає в тому, що види тварин, які живуть у цьому середовищі існування, залежать від хімічних речовин, присутніх у теплій воді, а не від сонця, щоб вижити. У цьому середовищі існування водяться такі види, як помпейський черв’як, гігантський трубчастий черв’як, присадкуватий омар із гідротермального джерела та риба з гідротермального джерела вугор.
Існують також численні інші типи середовищ існування, у тому числі середовищ існування листяних лісів, прибережних ареалів, сільськогосподарських угідь, полярних ареалів, міських ареалів, скелястих басейнів і морського дна, які населені численними видами ссавців, рептилій, амфібій, птахів, риб і безхребетних.
Середовища існування бактерій
Історія бактерій почалася близько 4 мільярдів років тому. За 2 мільярди років ці найпростіші організми майже не змінилися, хоча поруч з ними з’являлися, змінювалися і гинули інші, більш складні організми.
Ви вже знаєте
- бактерії – це група організмів, що входять до складу п’яти царств;
- До бактерій належать організми, які не мають клітинного ядра.
Ти навчишся
- описати, де знаходяться бактерії;
- описувати життєдіяльність бактерій;
- представляють позитивне і негативне значення бактерій.
1. Середовище існування бактерій
Без перебільшення можна сказати, що бактерії є всюди: у воді, ґрунті та повітрі. Завдяки своїм мікроскопічним розмірам вони легко переносяться потоками повітря на частинки пилу або краплі води. У кожного виду бактерій свої вимоги до типу субстрату, температури навколишнього середовища і доступу кисню. Багато бактерій живуть на поверхні тіла організмів або всередині них, тому що там вони мають потрібну температуру, вологу і достатню кількість їжі.

Деякі види бактерій зустрічаються в екстремальних умовах. Вони можуть жити в холодних льодовиках і гарячих джерелах. Вони зустрічаються як в глибинах океанів, де високий тиск, так і в найвищих шарах атмосфери. Вони трапляються на радіоактивно забруднених територіях і всередині вулканів, навіть ізольовані від нафтових покладів. Заселення таких різноманітних середовищ можливе завдяки їхній здатності швидко розмножуватися та пристосовуватися до мінливих умов. У результаті кожне середовище населене потрібними типами бактерій, що відрізняються за вимогами, харчуванням і диханням.
Спостереження 1
Спостереження за змінами, що відбуваються під час соління буряків.Що знадобиться
- свіжий буряк,
- вода,
- банку ємністю 1 л.
Інструкція
- Викладіть в банку вимиту і нарізану буряк.
- Налийте в банку теплої кип’яченої води, щоб вона покрила шматочки буряка.
- Накрийте банку чистою тканиною і поставте культуру в тепле і темне місце.
- Протягом 3-5 днів спостерігати за зміною зовнішнього вигляду, смаку і запаху води і буряків.
- Результати спостережень запишіть у зошит.
Резюме
Якщо рідина в банці помутніла і має різкий запах, а смак у неї явно кислуватий, це означає, що бактерії значно збільшилися і ведуть інтенсивну активність. Кислий смак рідини походить від молочної кислоти, яку виробляють бактерії.Команда 1
Поясніть, як клітини бактерій можуть опинитися в повітрі. Виходячи з цього, складіть рекомендації, як захистити себе та оточуючих від небажаного контакту з бактеріями.
Кумедний факт
Місця, де найчастіше зустрічаються бактерії, це дверні ручки, ручки в автобусах і трамваях, поверхні телефонів і комп’ютерних клавіатур, а також кухонні обробні дошки, а також ганчірки і губки. Дослідження показують, що сидіння та унітази зазвичай набагато чистіші.Кумедний факт
Бурякова кислота є цінним джерелом вітамінів групи В і мінеральних солей, особливо сполук заліза. Вміщені в ньому молочні бактерії підтримують роботу травної системи.
2. Різноманітність бактерій
Бактерії — найменші одноклітинні організми на Землі. Їх розмір коливається від 0,2 мкм до приблизно 10 мкм. Якщо бактеріальні клітини розташовувати одна за одною, то на ділянці 1 мм їх вмістилося б близько 1000. Деякі види бактерій утворюють колонії, в яких окремі клітини після поділу залишаються з’єднаними одна з одною клітинними стінками або слизом. Якщо бактерія відділяється від колонії, вона може функціонувати як окремий одноклітинний організм і дати початок іншій колонії.
Бактеріальні клітини набувають різноманітних форм, від чого вони часто називаються. До них відносяться кулясті коки , подовжені палички і палички , а також спіральні вібрації , спіралі і спірохети . Коки можуть об’єднувати дві клітини в т. зв два . Пакети утворюють правильні пучки, стафілококи – грудочки неправильної форми, що нагадують гроно винограду, а стрептококи – довгі ланцюжки, схожі на намистини. Форма клітин і зовнішній вигляд колоній є характеристиками конкретного виду бактерій.

Команда 2
Виготовте з пластиліну або іншої пластичної маси моделі клітин бактерій.Кумедний факт
У 1997 році в донних відкладеннях біля узбережжя Африки був виявлений вид найбільшої з відомих бактерій. Розмір їхніх клітин може досягати 0,75 мм, що означає, що їх можна побачити без використання оптичних приладів. Вони жовтого кольору і скріплені слизовим покриттям. Вони утворюють колонії, що нагадують нитку намистин.
3. Живлення бактерій
Бактерії, незважаючи на невеликі розміри і тіло, що складається з однієї клітини, здійснюють всю життєдіяльність. Вони харчуються, дихають, виділяють, розмножуються та ростуть, а також чутливі до факторів навколишнього середовища.
Переважна більшість бактерій харчується гетеротрофами , черпаючи поживні речовини з навколишнього середовища. Серед них є сапробіонти , їжею яких є мертва органічна речовина. Вони виділяють травні ферменти в субстрат, а перетравлені поза клітинами речовини поглинаються всією поверхнею тіла. Таким чином ґрунтові бактерії розкладають екскременти тварин або їхні трупи та залишки рослин. Подібним чином діють зубні бактерії, що живляться залишками їжі, що залишилися після їжі в ротовій порожнині, молочнокислі бактерії, що викликають скисання молока і маринованих овочів, і відповідальні за псування їжі.
Багато видів бактерій є паразитами , які живляться за рахунок інших організмів. Всередину вони потрапляють через травний тракт із з’їденою їжею або випитою водою, через дихальні шляхи з вдихуваним повітрям або через рани. Зазвичай вони проникають у рослини через пошкоджені тканини. Вони також викликають інфекційні захворювання.
Деякі гетеротрофні бактерії живуть з іншими організмами в симбіозі , тобто у відносинах, які приносять користь обом сторонам, і називаються симбіонтами. Симбіонт є джерелом живлення для бактерій і забезпечує сприятливе середовище для життя. Бактерії, в свою чергу, забезпечують його необхідними речовинами і полегшують життєві процеси.
Бактеріальне харчування
| СПОСОБИ ЖИВЛЕННЯ БАКТЕРІЙ | |
| неоднорідний | самоокупність |
| сапрофіти, включаючи симбіотичні бактерії , паразити | фотосинтетичний хемосинтетичний |

Серед бактерій є невелика група автотрофних організмів . До них відносяться ціанобактерії, які виробляють поживні речовини за допомогою фотосинтезу. Їх клітини містять необхідний хлорофіл і допоміжні пігменти синього і червоного кольорів. Разом вони надають клітинам ціанобактерій характерний блакитний колір. Ціанобактерії мешкають у прісних і солоних водах. Їхні предки були першими організмами на Землі, здатними до фотосинтезу. Завдяки їм близько мільярда років тому в атмосфері з’явився кисень.
Команда 3
Назвіть і опишіть живлення бактерій, що містяться в:
- в білому сирі,
- на руках
- в рані (наприклад, бактерії, що викликають нагноєння ран).
Кумедний факт
Невелику, але важливу групу автотрофних бактерій складають бактерії, які здійснюють хемосинтез. Вони виробляють їжу, використовуючи енергію, отриману від розкладання неорганічних речовин, присутніх у субстраті. До них відносяться, наприклад, сірчані бактерії, для яких джерелом енергії є сірководень, отруйний для більшості організмів.Кумедний факт
Поверхня ротової порожнини і зуби вкриті бактеріями зубного нальоту. Вони харчуються залишками їжі, що накопичуються між зубами і в ясенних кишенях. Вони розщеплюють цукор у їжі та виробляють кислоти, які послаблюють зубну емаль, захисний шар, який покриває зуби. Це може призвести до утворення порожнин у тканинах зуба. Найкращий захист від зубних бактерій – це ретельно чистити зуби після кожного прийому їжі.
4.Дихання бактерій
Бактерії, як і всі організми, вивільняють необхідну їм для життя енергію в процесі клітинного дихання. Ті, хто живе в середовищі, багатому киснем, дихають киснем, розщеплюючи органічні сполуки на вуглекислий газ і воду. Види бактерій, які мешкають в анаеробних або дуже бідних на кисень середовищах, виробляють енергію без використання цього елемента. Процес анаеробного дихання, в якому джерелом енергії є цукор, називається бродінням. З іншого боку, коли джерелом енергії є білок, відбувається процес гниття.
5. Розмноження бактерій
Бактерії розмножуються переважно поділом клітин і брунькуванням . При правильній температурі та вологості та достатньому доступі до їжі бактерії швидко розмножуються, і їх кількість може подвоюватися приблизно кожні 20 хвилин. На щастя, цей процес не триває вічно. Відсутність їжі та накопичення токсичних продуктів життєдіяльності гальмують ріст колонії. В результаті кількість живих особин зменшується.
6. Значення бактерій
Усі середовища функціонують завдяки бактеріям. Якби грунтові бактерії раптово зникли, вся Земля була б покрита величезною кількістю мертвих рослин і тварин, а мінеральні речовини в грунті були б вичерпані. Бактерії разом з грибами і деякими протистами розкладають мертву органіку, виділяючи з неї елементи і прості органічні сполуки. Завдяки цьому ці речовини можуть бути поглинені рослинами і знову включені в їх організми. Речовини рослинного походження, споживані споживачами, потрапляють в їхні тіла. Після загибелі останніх органічні сполуки знову стають їжею для мікроорганізмів. Таким чином бактерії та інші сапробіонти забезпечують кругообіг речовин у природі .
Бактерії, які утворюють нарости на коренях бобових культур , таких як горох, допомагають цим рослинам поглинати мінерали з навколишнього середовища. Співпраця бактерій з травоїдними дозволяє перетравлювати головний компонент рослинної їжі – целюлозу. На тілі людини та всередині нього є різні види бактерій, більшість з яких є симбіотичними організмами, які виконують корисну функцію. Лише деякі є патогенними організмами. Одним з найбільш поширених видів є кишкова паличка, яка зустрічається в товстому кишечнику. Він допомагає перетравлювати їжу і виробляє деякі вітаміни. Однак за певних умов він може викликати серйозні захворювання: інфекції сечовивідних шляхів, менінгіт у новонароджених, харчові отруєння.

Середовище існування риб
Риби потребують води та широкого розмаїття занурених структур, щоб забезпечити їм належні умови існування для підтримки стійких популяцій. Термін «середовище існування» загалом означає територію (чи території), в межах якої задовольняються вимоги всіх життєвих етапів виду*. Це може відбуватися на невеликій території або складатися з різноманітних середовищ існування на широкому ландшафті. Територія, де поповнення (нової риби) відбувається в масштабах, достатніх для підтримки популяції, може відрізнятися від середовища проживання дорослої особини, де відбувається годування та зростання. Наприклад, золотистий окунь може використовувати водяні заплави як місця проживання, але повертатися до річкової системи на решту свого життєвого циклу. Де такий вид, як золотистий окуньможуть мігрувати на багато кілометрів між середовищами існування, інші, як-от галактики Барред, живуть у невеликих гірських потоках і мають більш обмежене, спеціалізоване середовище існування.

Середовище існування включає як абіотичні (неживі), так і біотичні (живі) компоненти. Абоїтові компоненти включають геоморфологію водного тіла (дна, береги, форма), характеристику течії (висока, низька, швидка, повільна) і тип субстрату (наприклад, гравій або пісок), а також хімічний склад води. У більшості випадків ці характеристики дуже динамічні у внутрішніх водах Австралії, і вони безпосередньо впливають на рибу та інші живі істоти.
Широкі типи ареалів

У прісноводних середовищах існує два широких типи середовищ існування: лотичні (проточні води) і лентичні (непроточні води).
Багато місць проживання, таких як річки та струмки, утворюються завдяки взаємодії між ландшафтом, геологією, кліматом і рослинністю, де вони розташовані. Інтенсивність, частота та тривалість опадів, а також градієнт поєднуються, щоб накласти енергію на русло річки. Це створює важливі для риби структури, такі як послідовність басейнів/переливів, різноманітність субстрату (русла річки), підрізані береги тощо.
Річки та струмки взаємодіють у трьох вимірах.
- Поздовжньо – відбувається загальна зміна вздовж русла від швидкоплинних високогірних схилів до низинних, повільно текучих і часто звивистих водотоків. Підтримка поздовжнього зв’язку важлива для того, щоб риби могли отримувати доступ до різних середовищ існування на різних етапах свого життєвого циклу.
- Латерально – водотоки з’єднуються з їхньою заплавою, часто з’єднуючись із лінзовими місцями існування, такими як заплавні водно-болотні угіддя. Підтримка зв’язку із заплавою є важливою для підтримки життєвих циклів багатьох риб.
- Вертикально – це охоплює зв’язки з підстилаючим субстратом і грунтовими водами. Зміни рівня ґрунтових вод вплинуть на гідрологію річки та, можливо, на якість води (наприклад, проникнення солоних вод).
Лентові місця існування характеризуються загальною відсутністю течії, особливо в ізольованих озерах. Найпоширеніші природні лінзові місця існування в басейні Муррей-Дарлінг пов’язані із заплавами. Ці заплави можуть набути багатьох характеристик лотичних середовищ існування під час повеней, що виходять за межі берега. Постійні заплавні водно-болотні угіддя (ті, що не висихають) утворюють важливий притулок для риби, коли решта заплави висихає.
З моменту заселення європейцями в результаті будівництва дамб і гребель кількість лентичних місць існування значно зросла. Значна частина нижньої течії Муррей протягом значних періодів часу нагадує лінзове середовище існування через кількість шлюзів уздовж її довжини, і це призвело до відсутності різноманітності течії.
Різноманітність середовища існування
У широких типах середовищ існування lentic і lotic існує велика різноманітність умов, включаючи варіації течії, типи субстрату (матеріалу ґрунту), структури в течії (наприклад, затори колод), глибину, затінення (що впливає на температуру тощо) та хімічний склад води. Це призводить до широкого діапазону середовищ існування, які риби використовують на різних етапах свого життєвого циклу. Koehn і Kennard (2013) розрізняють мезоареали (наприклад, рифли та басейни) та мікроареали (зони різної глибини, субстрату, покриття тощо в басейні чи рифлі).
Ця різноманітність середовищ існування життєво важлива для внутрішніх риб і змінюється як у просторі, так і в часі. Риби переміщуються між цими середовищами існування, щоб отримати доступ до ресурсів залежно від своїх уподобань середовищ існування на різних етапах свого життєвого циклу. У той час як доступна деяка інформація про переваги мезоареалу багатьох прісноводних риб (наприклад, доросла тріска Murray найчастіше пов’язана з глибокими басейнами з течією; південний карликовий окунь віддає перевагу повільним або тихим водам, пов’язаним з водною рослинністю), набагато менше відомо про мікроареал. уподобання.
Здорові популяції риб потребують хорошого середовища проживання
З моменту поселення європейців у басейні Муррей-Дарлінг відбулася значна деградація середовища існування. Це призвело до зменшення чисельності та поширення місцевих риб. Впливи включають; регулювання або модифікація річкових потоків, фізична зміна середовищ існування (інфраструктура, річкова техніка), видалення зачіпів, видалення прибережної рослинності, ерозія та замулення, спричинені поганим управлінням землею, зміни якості води (наприклад, підвищення солоності), перешкоди для риби пересування, що зменшує доступ до критичного середовища існування, інтродукція чужорідних видів (наприклад, коропа) тощо.
Стратегія місцевих риб (NFS), оприлюднена в 2003 році, почала розглядати численні причини погіршення стану річкових систем у всьому басейні Мюррей-Дарлінг з метою відновлення середовищ існування та популяцій риб протягом 50-річного періоду. Програма сприяла відновленню середовища проживання шляхом залучення місцевих громад до відновлення ділянок річок і демонстрації переваг для місцевих популяцій риб і здоров’я річки в цілому.
Майбутня реабілітаційна діяльність продовжує базуватися на досвіді Стратегії місцевих риб і зосереджується на захисті та відновленні критичних середовищ існування риб (наприклад, рефугіумів від посухи), підтримці зв’язку між середовищами існування та підтримці різноманітності та якості середовищ існування в басейні. Дії повинні продовжувати підкріплюватися науковою базою та адаптивним підходом до управління.
Середовище існування тварин

Місце проживання організмів називають середовищем існування. Він забезпечує їжу, воду, повітря та притулок для організмів. Рослини, тварини та мікроорганізми співіснують разом в одному середовищі існування. Існують також різні типи середовищ існування, починаючи від гарячих пустель і закінчуючи холодними гірськими вершинами. Давайте розглянемо різних тварин, які живуть у різних середовищах існування.
Що таке Хабітат?
В екології середовище існування визначається як природне середовище, яке може підтримувати виживання та розмноження певного виду протягом року або протягом коротших періодів часу. Такі середовища існування складаються з біотичних і абіотичних факторів, а також інших ресурсів, які підтримують життя.
Що таке мікрожиттєдіяльність?
Мікросередовище існування – це менше середовище, яке дещо відрізняється від навколишнього середовища проживання. Такі середовища існування містять унікальні види, які не зустрічаються у більших середовищах існування. Наприклад, тимчасовий басейн з водою, нижня частина скелі або колода, що розкладається, є прикладами мікросередовища.
Які існують типи середовищ існування?
Середовища існування можна умовно розділити на два типи. Це наземні та водні середовища проживання. Тварини, які живуть на суші, називаються наземними. Існує широкий спектр наземних середовищ існування, таких як ліси, луки, пустелі, гірські хребти, прибережні регіони, водно-болотні угіддя, крижані шапки та заболочені території. Кажуть, що тварини, які живуть у водоймах, таких як річки, озера, ставки та океани, знаходяться у водних середовищах існування. Тварини мають різні пристосування, які роблять їх придатними для проживання в певному середовищі існування.
Наземні середовища проживання
Середовища існування, присутні на поверхні землі, відомі як наземні середовища проживання. Тварини вдихають кисень з повітря легенями. Вони мають ноги, щоб ходити по землі, а деякі мають крила, щоб літати в небі. Деякі з наземних середовищ існування – це ліси, луки, пустелі та водно-болотні угіддя.
- Ліси
- Помірний
- Тропічний
- Бореальний
- Сніжний ліс
- Лугові угіддя
- Тропічні луки
- Помірні луки
- Пустелі
- Спекотні і сухі пустелі
- Прибережні пустелі
- Холодні пустелі
- Напівзасушливі пустелі
- Водно-болотні угіддя
- Болота
- Ставки
- Болота
- Торф’яні болота
Водне середовище існування
Водні середовища існування називаються водними. Тварини у водних середовищах існування використовують для дихання розчинений у воді кисень. Для цього у них є зябра. У них є ласти, щоб плавати у воді. Водні середовища проживання можуть бути морськими або прісноводними.
- прісноводні
- Річки
- озера
- Потоки
- морський
- Пелагічні середовища існування (відкрите море, крім узбережжя та морського дна)
- Донні місця існування (дно океану та вода біля нього)
Часті запитання про середовище проживання тварин
Як дихають наземні тварини?
Наземні тварини дихають легенями. Вони використовують молекулярний кисень, присутній у повітрі.
Які водні пристосування тварин?
Водні тварини дихають зябрами і поглинають розчинений у воді кисень.
Назвіть тварин бореальних лісів?
Лось, лемінги та ведмеді грізлі – тварини, що живуть у бореальних лісах.
Що таке мікрожиттєдіяльність?
Мікроареал існування – це менше середовище, яке дещо відрізняється від навколишнього середовища існування та містить унікальні види, яких немає у більшому середовищі існування. Наприклад: нижня сторона скелі, колода, що розкладається.